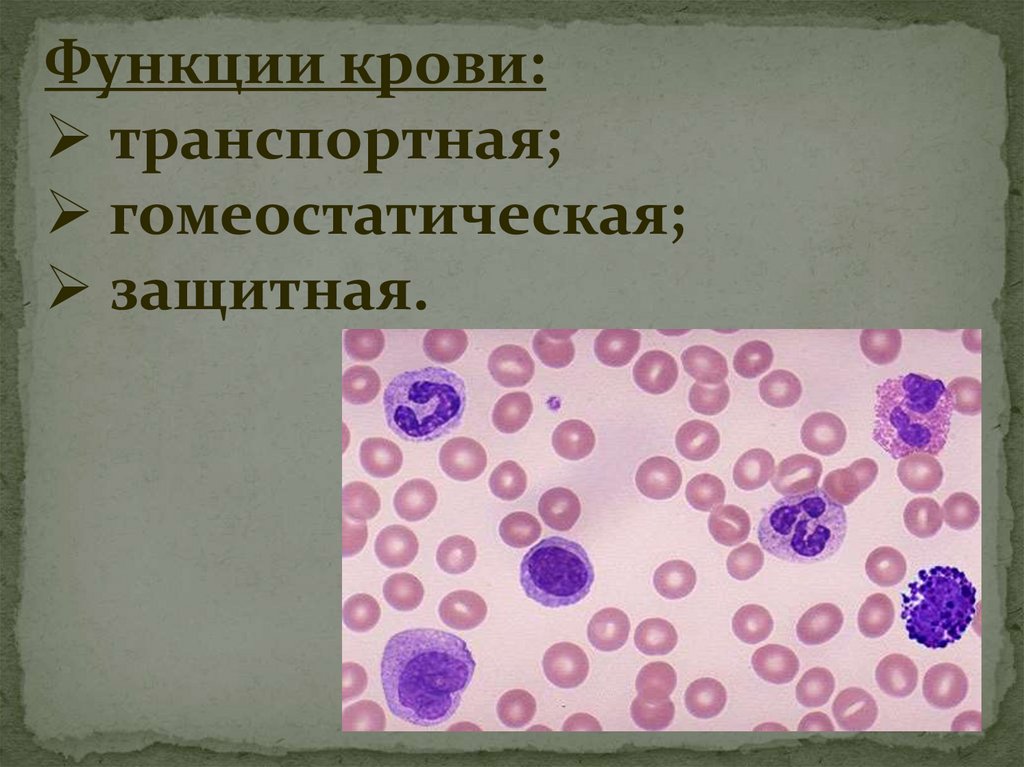
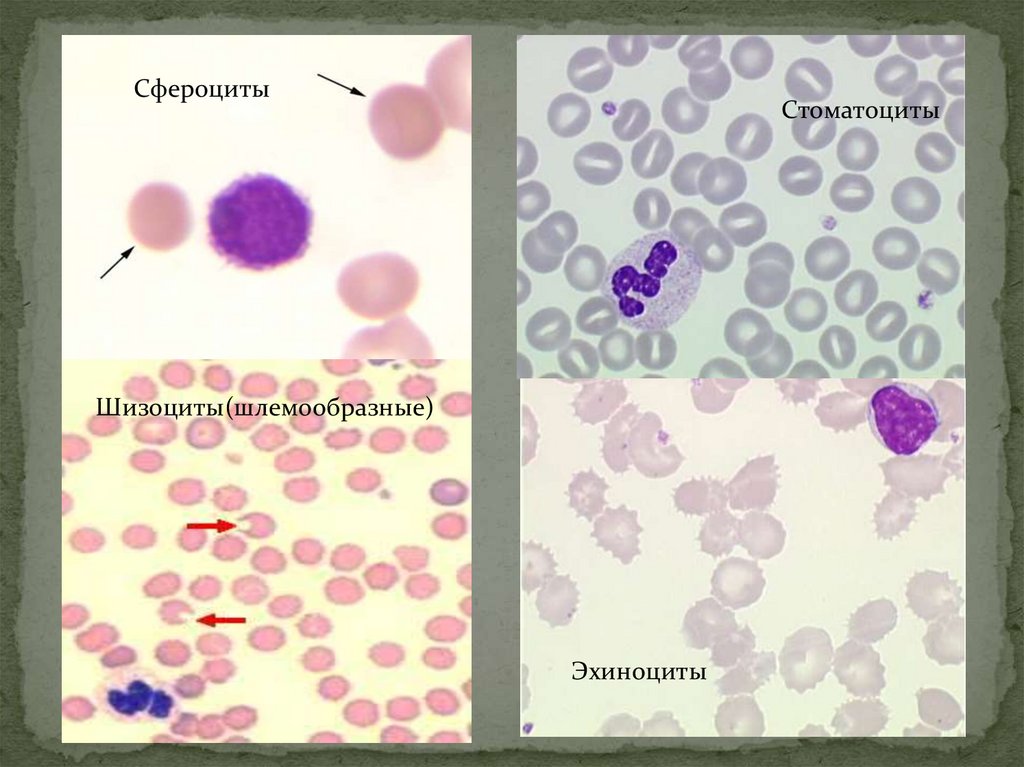

Похожие презентации:
Кровь и лимфа. Гемопоэз
1.
2.
Система тканей внутренней средывключает:
1. Кровь и лимфа.
2. Соединительные ткани:
а) собственно соединительные
ткани;
б) соединительные ткани со
специальными свойствами;
в) скелетные ткани – хрящевая и
костная
3.
Система кровивключает в себя:
1. Кровь.
2. Органы кроветворения –
красный костный мозг, тимус,
селезенку, лимфатические узлы.
3. Лимфоидную ткань
некроветворных органов.
4.
5.
6.
Функции крови:транспортная;
гомеостатическая;
защитная.
7.
Плазма крови – межклеточное веществожидкой консистенции.
Состоит из воды (90%), органических (9%) и неорганических веществ (1%).
Белки составляют ≈ 6% всех веществ плазмы.
Выделяют 3 основные группы белков плазмы:
1. Белки системы свертывания:
Коагулянты – плазменные факторы свертывания.
Антикоагулянты - компоненты фибринолитической системы, т.е.
препятствующие свертыванию.
2. Иммунные белки – это Ig и белки комплемента. Ig (АT) – белки γглобулиновой фракции. Различают несколько классов Ig. Они участвуют в
реакциях «Аg + АT», инактивируют вирусы, токсины, бактерии. Белки
комплемента участвуют в неспецифической защите клеток хозяина и
инициируют реакции воспаления.
3. Транспортные белки – альбумины, трансферрин, аполипопротеины,
гаптоглобин, транскобаламины и др.
8.
эритроциты;лейкоциты;
тромбоциты
(кровяные пластинки).
9.
Количество:у мужчин у женщин -
Основная функция –
транспорт О2 и СО2
3,9 – 5,5 ∙ 1012/л
3,7 – 4,9 ∙ 1012/л
10.
Гемоглобин11.
Сфероциты – шаровидной формыЭхиноциты – с многочисленными шипиками
стареющие формы эритроцитов
Акантоциты – с небольшим количеством шипиков
кренирование (образование зубцов на плазмолемме)
Планоциты – с плоской поверхностью
Стоматоциты – с щелевидным просветлением в центре
Шизоциты – шлемообразной формы
Дрепаноциты – серповидной формы
Эллиптоциты – эллиптоидной формы
Дакроциты – каплевидной формы
Кодоциты – в виде мишени
Анулоциты – с отверстием в центре
12.
СфероцитыСтоматоциты
Шизоциты(шлемообразные)
Эхиноциты
13.
14.
ГранулоцитыАгранулоциты
Нейтрофилы
Лимфоциты
Эозинофилы
Базофилы
Моноциты
15.
16.
17.
18.
Эмбриональный гемопоэзпроходит в три этапа:
1. Мегалобластический
2. Гепатотимолиенальный
3. Медуллярнолимфатический

Медицина
Медицина








